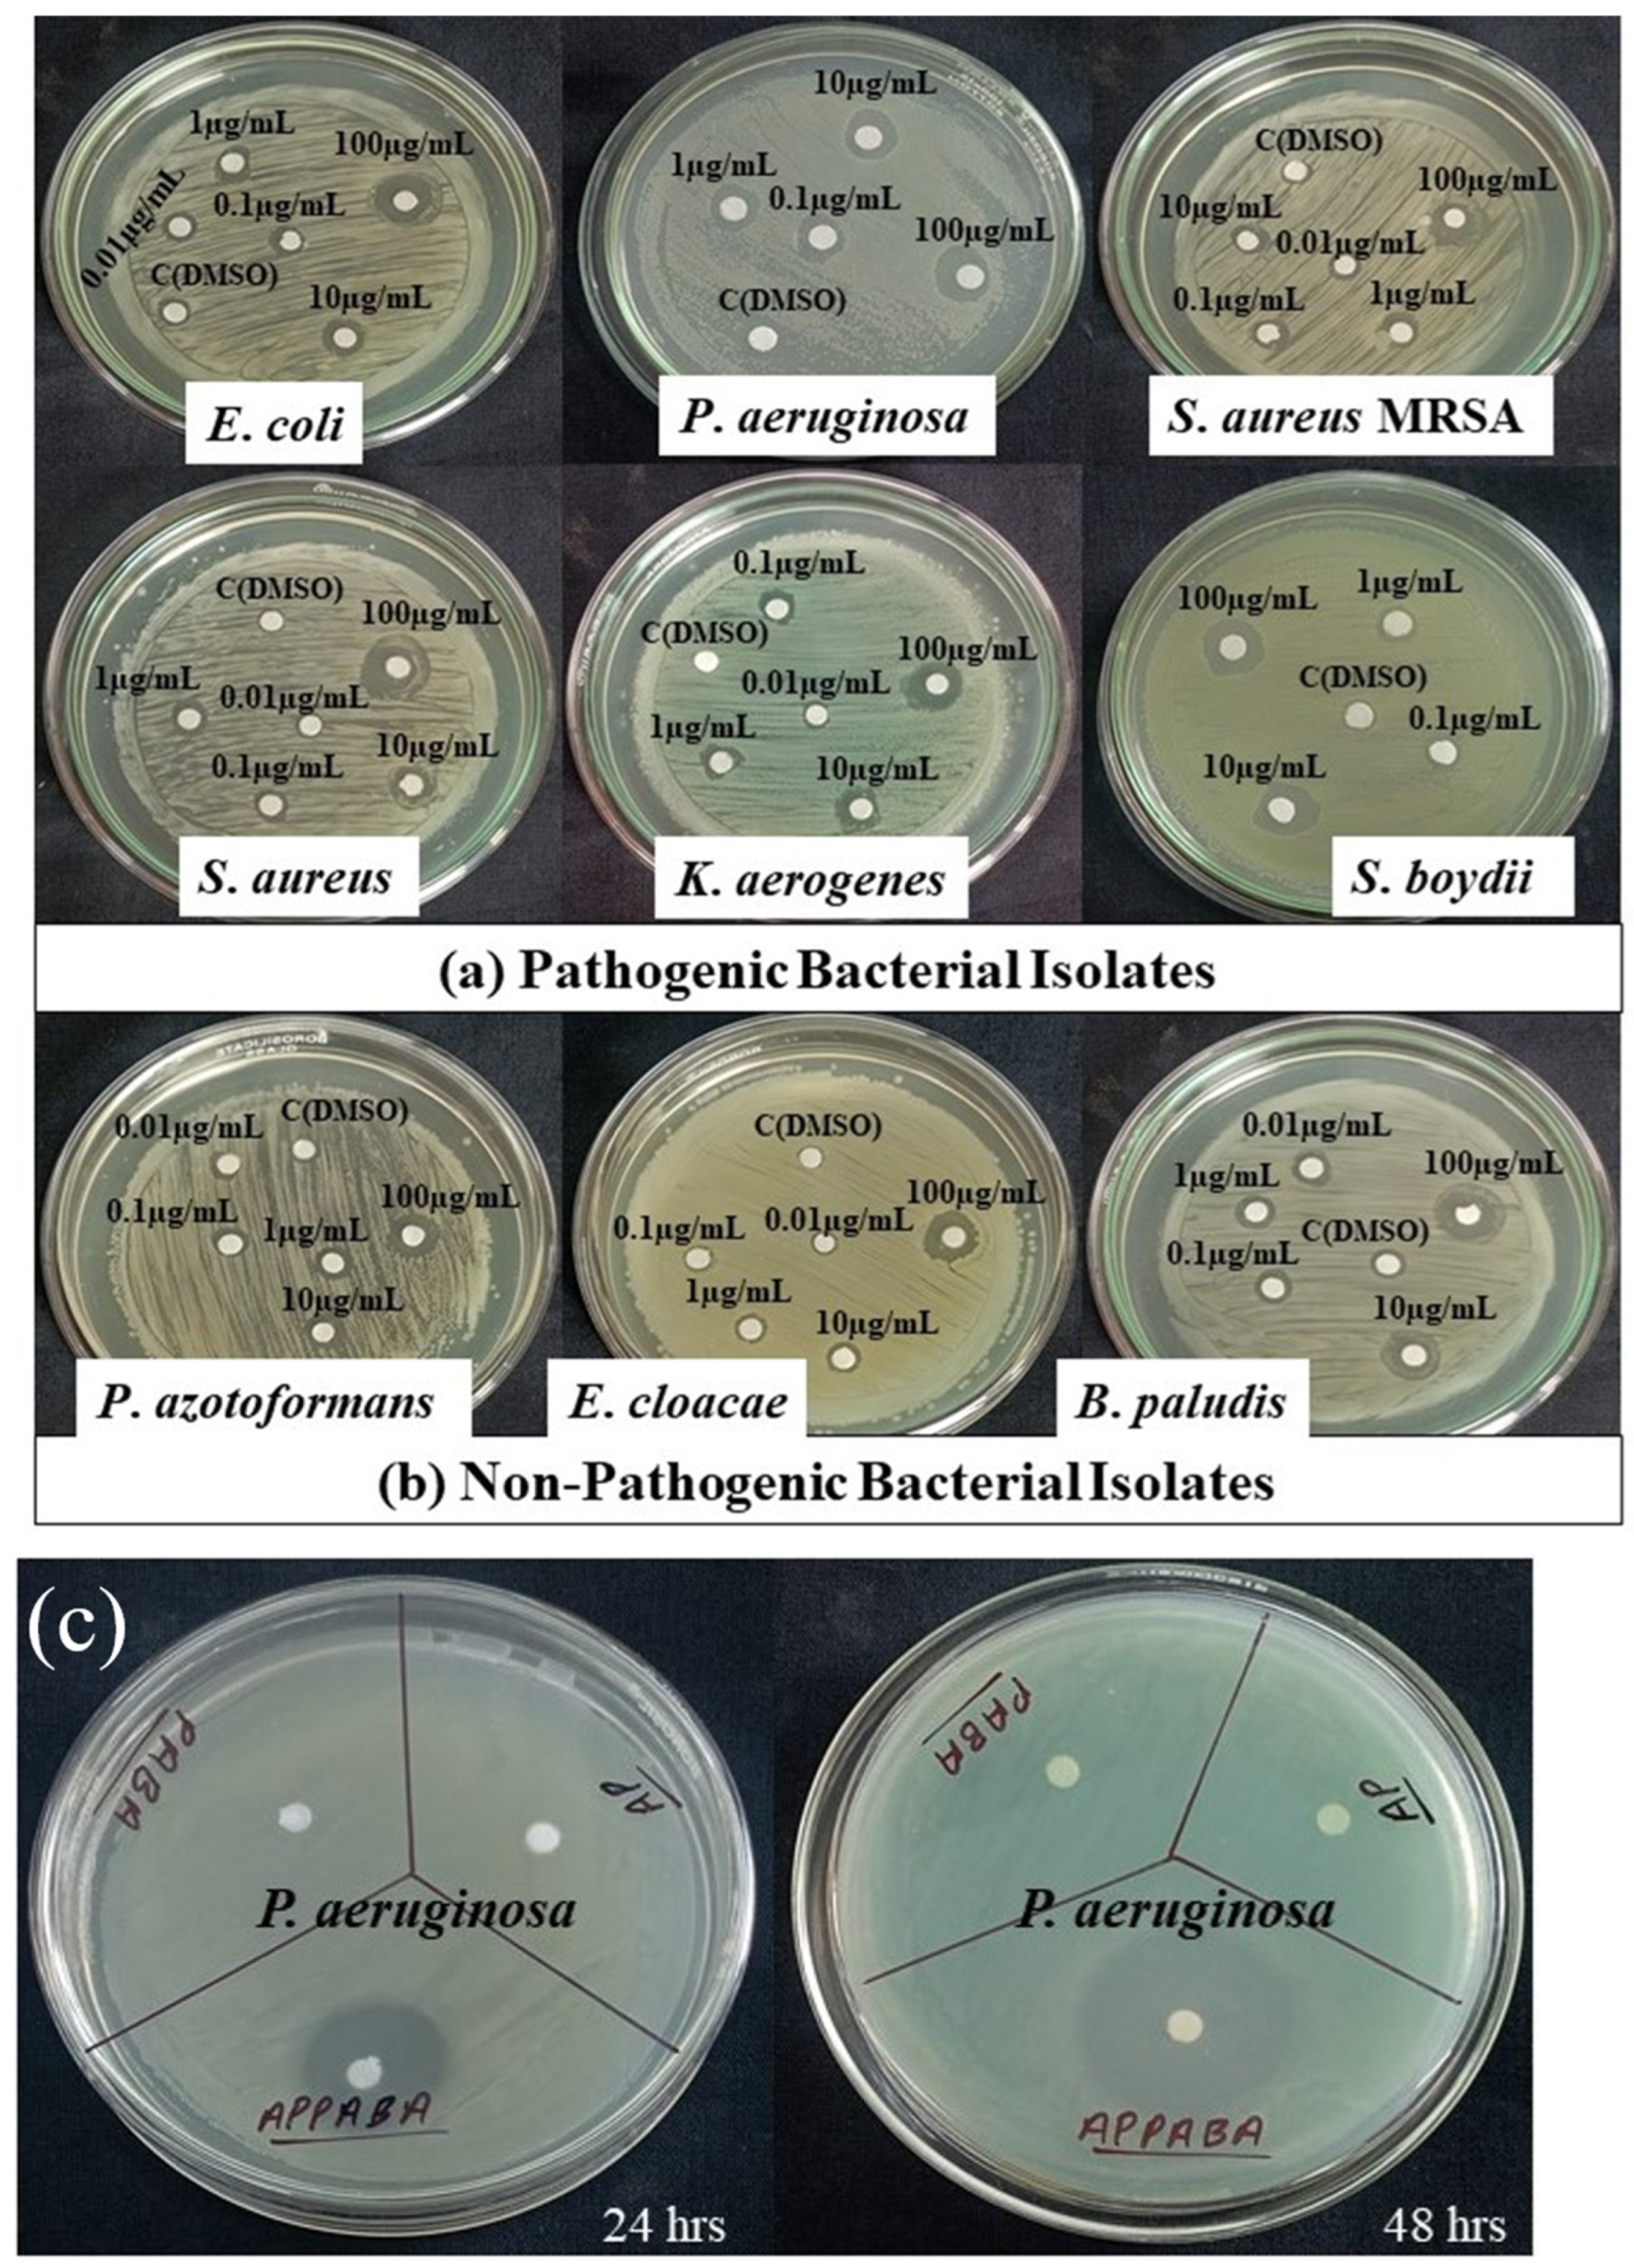
Ijms 26 05509 g012

Green Solid-State Synthesis of Antibacterial Binary Organic Material: Crystal Growth, Physicochemical Properties, Thermal Study, Antibacterial Activity, and Hirshfeld Surface Analysis
Abstract
1. Introduction
2. Results and Discussion
2.1. Phase Diagram Analysis
2.2. Spectral Studies
2.2.1. FTIR Absorption Studies
2.2.2. NMR Studies
- NMR spectrum of 2-aminopyrimidine (AP)
- NMR spectrum of 4-aminobenzoic acid (PABA)
- NMR spectrum of intermolecular compound (APPABA)
2.2.3. Mass Spectral Analysis
2.3. X-Ray Diffraction Studies
2.3.1. Powder X-Ray Diffraction
2.3.2. Single-Crystal Growth and Single-Crystal Diffraction
2.3.3. Hirshfeld Surface Analysis
2.4. Thermochemistry and Thermodynamic Studies
2.4.1. Differential Scanning Calorimetry and Thermal Studies
2.4.2. Excess Thermodynamic Function
2.5. Optical Studies
2.5.1. UV–Vis Absorption Studies
2.5.2. Emission Studies
2.6. Antibacterial Activity
3. Materials and Methods
3.1. Materials and Purification
3.2. Phase Diagram Study
3.3. Thermal Study
3.4. Spectral Study
3.5. Powder X-Ray Diffraction Study
3.6. Single-Crystal Growth and X-Ray Diffraction Study
3.7. Optical Study
3.8. Antibacterial Studies
4. Conclusions
- (1)
- The solid-state green synthesis approach employed for the synthesis of APPABA offers several significant advantages compared to other synthesis methods. This approach is environmentally friendly, eliminates the use of solvents, is less complex, time-efficient, and cost-effective compared to other organic synthesis methods. The use of only melting temperatures for synthesis, avoiding solvents and complexity, enhances its practicality and accessibility in both academic and industrial applications.
- (2)
- The compositional behaviour as a function of melting temperature has been studied by establishing the solid–liquid phase equilibrium diagram, which suggests the formation of a 1:1 intermolecular compound (IMC) and two eutectics. The DSC studies confirmed the purity and single-phase transition of the IMC during melting.
- (3)
- Spectral studies of the IMC confirmed the formation of hydrogen bonds, showing that the two molecules are joined together via hydrogen bonding between the carboxylic group of PABA and both the amine group and the ring nitrogen atom of AP. The optical studies suggest that the IMC (APPABA) is significantly fluorescent. Additionally, the single-crystal X-ray diffraction study of the grown crystal of IMC confirms its crystal structure to be monoclinic with a P21/n space group.
- (4)
- The antibacterial activity of APPABA, tested through inhibition zone assays, showed a range of 6.75–9.75 mm for pathogenic strains and 4–8.75 mm for non-pathogenic strains. APPABA was particularly effective in inhibiting the methicillin-resistant bacterial strain Staphylococcus aureus (MRSA). The MIC of APPABA against all the selected bacterial strains was 0.1 µg/mL, which was comparable to the selected antibiotics. Furthermore, an expanding antibacterial zone, from 14 mm to 25 mm, was observed over time against the pathogenic Pseudomonas aeruginosa.
Supplementary Materials
Author Contributions
Funding
Institutional Review Board Statement
Informed Consent Statement
Data Availability Statement
Acknowledgments
Conflicts of Interest
References
- Kaczmarek, B. Tannic Acid with Antiviral and Antibacterial Activity as A Promising Component of Biomaterials—A Minireview. Materials 2020, 13, 3224. [Google Scholar] [CrossRef] [PubMed]
- Chaudhary, S.; Rai, R.N.; Jyothi, D.; Singh, U.P. Solid State Synthesis, Thermal, Spectral, Optical, Crystal Structure and Atomic Packing Studies of 2-(3-Hydroxyphenyl)-2,3-Dihydroquinazolin-4(1H)-One. Mater. Lett. 2023, 341, 134253. [Google Scholar] [CrossRef]
- Levin-Reisman, I.; Ronin, I.; Gefen, O.; Braniss, I.; Shoresh, N.; Balaban, N.Q. Antibiotic Tolerance Facilitates the Evolution of Resistance. Science 2017, 355, 826–830. [Google Scholar] [CrossRef]
- Worthington, R.J.; Melander, C. Combination Approaches to Combat Multidrug-Resistant Bacteria. Trends Biotechnol. 2013, 31, 177–184. [Google Scholar] [CrossRef]
- Hansen, E.; Karslake, J.; Woods, R.J.; Read, A.F.; Wood, K.B. Antibiotics Can Be Used to Contain Drug-Resistant Bacteria by Maintaining Sufficiently Large Sensitive Populations. PLoS Biol. 2020, 18, e3000713. [Google Scholar] [CrossRef] [PubMed]
- Yang, B.; Fang, D.; Lv, Q.; Wang, Z.; Liu, Y. Targeted Therapeutic Strategies in the Battle Against Pathogenic Bacteria. Front. Pharmacol. 2021, 12, 673239. [Google Scholar] [CrossRef]
- Saidahmatov, A.; Li, J.; Xu, S.; Hu, X.; Gao, X.; Kan, W.; Gao, L.; Li, C.; Shi, Y.; Sheng, L.; et al. Discovery of Novel 2-Aminopyridine-Based and 2-Aminopyrimidine-Based Derivatives as Potent CDK/HDAC Dual Inhibitors for the Treatment of Refractory Solid Tumors and Hematological Malignancies. J. Med. Chem. 2024, 67, 15220–15245. [Google Scholar] [CrossRef] [PubMed]
- İhsan Han, M.; İnce, U.; Gündüz, M.G.; Coşkun, G.P.; Birgül, K.; Doğan, Ş.D.; Küçükgüzel, Ş.G. Synthesis, Antimicrobial Evaluation and Molecular Modeling Studies of Novel Thiosemicarbazides/Semicarbazides Derived from p-Aminobenzoic Acid. J. Mol. Struct. 2022, 1261, 132907. [Google Scholar] [CrossRef]
- Jiang, J.; Hou, Y.; Duan, M.; Wang, B.; Wu, Y.; Ding, X.; Zhao, Y. Design, Synthesis and Antibacterial Evaluation of Novel Oxazolidinone Derivatives Nitrogen-Containing Fused Heterocyclic Moiety. Bioorg. Med. Chem. Lett. 2021, 32, 127660. [Google Scholar] [CrossRef]
- Mi, Y.; Zhang, J.; Han, X.; Tan, W.; Miao, Q.; Cui, J.; Li, Q.; Guo, Z. Modification of Carboxymethyl Inulin with Heterocyclic Compounds: Synthesis, Characterization, Antioxidant and Antifungal Activities. Int. J. Biol. Macromol. 2021, 181, 572–581. [Google Scholar] [CrossRef]
- Atukuri, D.; Gunjal, R.; Holagundi, N.; Korlahalli, B.; Gangannavar, S.; Akkasali, K. Contribution of -Heterocycles towards Anti-Tubercular Drug Discovery (2014–2019); Predicted and Reengineered Molecular Frameworks. Drug Dev. Res. 2021, 82, 767–783. [Google Scholar] [CrossRef] [PubMed]
- Brown, H.D.; Matzuk, A.R.; Ilves, I.R.; Peterson, L.H.; Harris, S.A.; Sarett, L.H.; Egerton, J.R.; Yakstis, J.J.; Campbell, W.C.; Cuckler, A.C. Antiparasitic drugs. IV. 2-(4′-thiazolyl)-benzimidazole, a new anthelmintic. J. Am. Chem. Soc. 1961, 83, 1764–1765. [Google Scholar] [CrossRef]
- McClellan, K.; Perry, C.M. Oseltamivir. Drugs 2001, 61, 263–283. [Google Scholar] [CrossRef]
- Wang, W.; Xiong, L.; Li, Y.; Song, Z.; Sun, D.; Li, H.; Chen, L. Synthesis of Lathyrane Diterpenoid Nitrogen-Containing Heterocyclic Derivatives and Evaluation of Their Anti-Inflammatory Activities. Bioorg. Med. Chem. 2022, 56, 116627. [Google Scholar] [CrossRef]
- Ngilirabanga, J.B.; Aucamp, M.; Samsodien, H. Mechanochemical Synthesis and Characterization of Zidovudine-Lamivudine Solid Dispersion (Binary Eutectic Mixture). J. Drug Deliv. Sci. Technol. 2021, 64, 102639. [Google Scholar] [CrossRef]
- Santos, F.; Duarte, A.R.C. Therapeutic Deep Eutectic Systems for the Enhancement of Drug Bioavailability. In Deep Eutectic Solvents for Medicine, Gas Solubilization and Extraction of Natural Substances; Fourmentin, S., Costa Gomes, M., Lichtfouse, E., Eds.; Springer International Publishing: Cham, Switzerland, 2021; pp. 103–129. ISBN 978-3-030-53069-3. [Google Scholar]
- Nugrahani, I.; Parwati, R.D. Challenges and Progress in Nonsteroidal Anti-Inflammatory Drugs Co-Crystal Development. Molecules 2021, 26, 4185. [Google Scholar] [CrossRef]
- Radhakrishnan, A.; Palanisamy, V.; Sanphui, P. Organic Molecular Salts of Allopurinol with Improved Solubility. Mater. Today Proc. 2021, 40, S210–S215. [Google Scholar] [CrossRef]
- Uma Maheswararao, G.; Jaya Krishna, D.; John, B. Melting and Solidification Behaviour of Some Organic Phase Change Materials Applicable to Low Temperature Heat Storage Applications. Int. J. Thermophys. 2022, 43, 113. [Google Scholar] [CrossRef]
- Dai, J.; Ma, F.; Fu, Z.; Li, C.; Jia, M.; Shi, K.; Wen, Y.; Wang, W. Applicability Assessment of Stearic Acid/Palmitic Acid Binary Eutectic Phase Change Material in Cooling Pavement. Renew. Energy 2021, 175, 748–759. [Google Scholar] [CrossRef]
- Tian, W.; Lin, J.; Zhang, H.; Duan, X.; Sun, H.; Wang, H.; Wang, S. Enhanced Removals of Micropollutants in Binary Organic Systems by Biomass Derived Porous Carbon/Peroxymonosulfate. J. Hazard. Mater. 2021, 408, 124459. [Google Scholar] [CrossRef]
- Heng, W.; He, X.; Song, Y.; Han, J.; Pang, Z.; Qian, S.; Zhang, J.; Gao, Y.; Wei, Y. Insights into Cocrystallization and Coamorphization Engineering Techniques in the Delivery of Traditional Chinese Medicine: Formation Mechanism, Solid-State Characterization, and Improved Pharmaceutical Properties. Cryst. Growth Des. 2022, 22, 5110–5134. [Google Scholar] [CrossRef]
- Saikia, B.; Seidel-Morgenstern, A.; Lorenz, H. Multicomponent Materials to Improve Solubility: Eutectics of Drug Aminoglutethimide. Crystals 2022, 12, 40. [Google Scholar] [CrossRef]
- Singaravelan, K.; Chandramohan, A.; Madhankumar, S.; Enoch, M.V.; Vinitha, G. Structural Characterization, Computational and Biological Studies of a New Third Order NLO (1:1) Organic Adduct: 2-Aminopyrimidine: 3-Nitrophthalic Acid. J. Mol. Struct. 2019, 1194, 57–65. [Google Scholar] [CrossRef]
- Filho, E.V.; Pina, J.W.S.; Antoniazi, M.K.; Loureiro, L.B.; Ribeiro, M.A.; Pinheiro, C.B.; Guimarães, C.J.; de Oliveira, F.C.E.; Pessoa, C.; Taranto, A.G.; et al. Synthesis, Docking, Machine Learning and Antiproliferative Activity of the 6-Ferrocene/Heterocycle-2-Aminopyrimidine and 5-Ferrocene-1H-Pyrazole Derivatives Obtained by Microwave-Assisted Atwal Reaction as Potential Anticancer Agents. Bioorg. Med. Chem. Lett. 2021, 48, 128240. [Google Scholar] [CrossRef]
- Thangarasu, S.; Siva, V.; Athimoolam, S.; Bahadur, S.A. Molecular Structure, Spectroscopic and Quantum Chemical Studies on Benzoic Acid and Succinic Acid Co-Crystals of 2-Aminopyrimidine. J. Theor. Comput. Chem. 2018, 17, 1850021. [Google Scholar] [CrossRef]
- Nagarajan, S.; Shanmugavelan, P.; Sathishkumar, M.; Selvi, R.; Ponnuswamy, A.; Harikrishnan, H.; Shanmugaiah, V.; Murugavel, S. An Eco-Friendly and Water Mediated Product Selective Synthesis of 2-Aminopyrimidines and Their in Vitro Anti-Bacterial Evaluation. Bioorg. Med. Chem. Lett. 2014, 24, 4999–5007. [Google Scholar] [CrossRef]
- Mohamed, M.S.; Awad, S.M.; Sayed, A.I. Synthesis of Certain Pyrimidine Derivatives as Antimicrobial Agents and Anti-Inflammatory Agents. Molecules 2010, 15, 1882–1890. [Google Scholar] [CrossRef]
- Wang, X.; Zhang, C.; Zhang, X.; Wang, J.; Zhao, L.; Zhao, D.; Cheng, M. Design, Synthesis and Biological Evaluation of 2-Aminopyrimidine-Based LSD1 Inhibitors. Bioorg. Chem. 2022, 121, 105699. [Google Scholar] [CrossRef]
- Ballell, L.; Field, R.A.; Chung, G.A.C.; Young, R.J. New Thiopyrazolo[3,4-d]Pyrimidine Derivatives as Anti-Mycobacterial Agents. Bioorg. Med. Chem. Lett. 2007, 17, 1736–1740. [Google Scholar] [CrossRef]
- Val, C.; Rodríguez-García, C.; Prieto-Díaz, R.; Crespo, A.; Azuaje, J.; Carbajales, C.; Majellaro, M.; Díaz-Holguín, A.; Brea, J.M.; Loza, M.I.; et al. Optimization of 2-Amino-4,6-Diarylpyrimidine-5-Carbonitriles as Potent and Selective A1 Antagonists. J. Med. Chem. 2022, 65, 2091–2106. [Google Scholar] [CrossRef]
- Zhang, B.; Zhang, Q.; Xiao, Z.; Sun, X.; Yang, Z.; Gu, Q.; Liu, Z.; Xie, T.; Jin, Q.; Zheng, P.; et al. Design, Synthesis and Biological Evaluation of Substituted 2-(Thiophen-2-Yl)-1,3,5-Triazine Derivatives as Potential Dual PI3Kα/mTOR Inhibitors. Bioorg. Chem. 2020, 95, 103525. [Google Scholar] [CrossRef] [PubMed]
- Large, J.M.; Birchall, K.; Bouloc, N.S.; Merritt, A.T.; Smiljanic-Hurley, E.; Tsagris, D.J.; Wheldon, M.C.; Ansell, K.H.; Coombs, P.J.; Kettleborough, C.A.; et al. Potent Inhibitors of Malarial P. Falciparum Protein Kinase G: Improving the Cell Activity of a Series of Imidazopyridines. Bioorg. Med. Chem. Lett. 2019, 29, 509–514. [Google Scholar] [CrossRef] [PubMed]
- Michael, R.; Richards, E.; Xing, D.K.L. The Effect of p-Aminobenzoic Acid on the Uptake of Thymidine and Uracil by Escherichia coli. Int. J. Pharm. 1995, 116, 217–221. [Google Scholar] [CrossRef]
- Singh, M.; Rai, R.N.; Rai, U.S. Synthesis, Crystal Growth and Physicochemical Studies on a Novel Organic Inter-Molecular Compound; 3,5-Dinitrobenzoic Acid and Salicylamide System. J. Cryst. Growth 2015, 419, 114–122. [Google Scholar] [CrossRef]
- Thangarasu, S.; Suresh Kumar, S.; Athimoolam, S.; Sridhar, B.; Asath Bahadur, S.; Shanmugam, R.; Thamaraichelvan, A. Synthesis, Structure, Spectral, Thermal Analyses and DFT Calculation of a Hydrogen Bonded Crystal: 2-Aminopyrimidinium Dihydrogenphosphate Monohydrate. J. Mol. Struct. 2014, 1074, 107–117. [Google Scholar] [CrossRef]
- Taylor, R.; Kennard, O. Hydrogen-Bond Geometry in Organic Crystals. Acc. Chem. Res. 1984, 17, 320–326. [Google Scholar] [CrossRef]
- Rai, U.S.; Mandal, K.D.; Singh, N.P. Thermochemical Studies on Organic Eutectics and Molecular Complexes. J. Therm. Anal. 1989, 35, 1687–1697. [Google Scholar] [CrossRef]
- Singh, N.; Singh, N.B.; Rai, U.S.; Singh, O.P. Structure of Eutectic Melts; Binary Organic Systems. Thermochim. Acta 1985, 95, 291–293. [Google Scholar] [CrossRef]
- Neupane, U.; Rai, R.N. Synthesis, Spectral Characterization, Thermal and Optical Studies of Novel Complexes: 4-(Dimethylamino)Benzylidene-4-Acetamideaniline and 4-(Dimethylamino)Benzylidene-4-Nitroaniline. J. Fluoresc. 2017, 27, 2263–2277. [Google Scholar] [CrossRef]
- Pavia, D.L.; Lampman, G.M.; Kriz, G.S.; Vyvyan, J.R. Introduction to Spectroscopy, 5th ed.; Brooks/Cole Cengage Learning: Boston, MA, USA, 2013; Chapter 10; ISBN 978-1-285-46012-3. [Google Scholar]
- Sarjono, P.R.; Putri, L.D.; Budiarti, C.E.; Mulyani, N.S.; Ngadiwiyana; Ismiyarto; Kusrini, D.; Adiwibawa Prasetya, N.B. Antioxidant and Antibacterial Activities of Secondary Metabolite Endophytic Bacteria from Papaya Leaf (Carica papaya L.). IOP Conf. Ser.: Mater. Sci. Eng. 2019, 509, 012112. [Google Scholar] [CrossRef]
- Prasad, J.K.; Dey, R.; Raghuwanshi, R. Exopolysaccharide-Producing Rhizospheric Bacteria Enhance Yield via Promoting Wheat (Triticum aestivum L.) Growth at Early Stages. Microbiology 2022, 91, 757–769. [Google Scholar] [CrossRef]
- Giovagnorio, F.; De Vito, A.; Madeddu, G.; Parisi, S.G.; Geremia, N. Resistance in Pseudomonas aeruginosa: A Narrative Review of Antibiogram Interpretation and Emerging Treatments. Antibiotics 2023, 12, 1621. [Google Scholar] [CrossRef]
- Ballén, V.; Gabasa, Y.; Ratia, C.; Ortega, R.; Tejero, M.; Soto, S. Antibiotic Resistance and Virulence Profiles of Klebsiella pneumoniae Strains Isolated from Different Clinical Sources. Front. Cell. Infect. Microbiol. 2021, 11, 738223. [Google Scholar] [CrossRef] [PubMed]
- Dean, J.A. Lange’s; Handbook of Chemistry, 15th ed.; McGraw-Hill, Inc.: New York, NY, USA, 1999; ISBN 0-07-016384-7. [Google Scholar]
- Chaudhary, S.; Rai, R.; Sahoo, K.; Kumar, M. Forecast of Phase Diagram for the Synthesis of a Complex for the Detection of Cr6+ Ions. ACS Omega 2022, 7, 7460–7471. [Google Scholar] [CrossRef] [PubMed]
- Dolomanov, O.V.; Bourhis, L.J.; Gildea, R.J.; Howard, J.a.K.; Puschmann, H. OLEX2: A Complete Structure Solution, Refinement and Analysis Program. J. Appl. Cryst. 2009, 42, 339–341. [Google Scholar] [CrossRef]
- Sheldrick, G.M. SHELXT—Integrated Space-Group and Crystal-Structure Determination. Acta Cryst. A 2015, 71, 3–8. [Google Scholar] [CrossRef] [PubMed]
- Sheldrick, G.M. Crystal Structure Refinement with SHELXL. Acta Cryst. C 2015, 71, 3–8. [Google Scholar] [CrossRef]
- Macrae, C.F.; Sovago, I.; Cottrell, S.J.; Galek, P.T.A.; McCabe, P.; Pidcock, E.; Platings, M.; Shields, G.P.; Stevens, J.S.; Towler, M.; et al. Mercury 4.0: From Visualization to Analysis, Design and Prediction. J. Appl. Cryst. 2020, 53, 226–235. [Google Scholar] [CrossRef]
- Pires, D.E.V.; Blundell, T.L.; Ascher, D.B. pkCSM: Predicting Small-Molecule Pharmacokinetic and Toxicity Properties Using Graph-Based Signatures. J. Med. Chem. 2015, 58, 4066–4072. [Google Scholar] [CrossRef]

| APPABA | |
|---|---|
| Empirical formula | C22H24N8O4 |
| T/K | 296 |
| Crystal System | Monoclinic |
| Space Group | P21/n |
| a/Å | 5.2428 (2) |
| b/Å | 17.9260 (5) |
| c/Å | 11.8917 (4) |
| α/° | 90 |
| β/° | 92.5750 (10) |
| γ/° | 90 |
| V/Å3 | 2416.5 (2) |
| Z | 2 |
| μ (Mo−Kα)/mm−1 | 0.099 |
| Reflections Collected/unique | 187.36/2754 |
| R (int) | 0.0381 |
| Final R indices [I > 2σ (I)] | R1 = 0.0440 wR2 = 0.1143 |
| R indices (all data) | R1 = 0.0554 wR2 = 0.1214 |
| GOF on F2 | 1.060 |
| CCDC No | 2235290 |
| Component | Melting Temperature (K) | Heat of Fusion (kJ mol−1) | Heat of Mixing (kJ mol−1) | Entropy of Fusion (kJ mol−1 K−1) |
|---|---|---|---|---|
| AP—PABA system | ||||
| AP | 398.41 | 18.32 | 0.0460 | |
| PABA | 462.58 | 20.73 | 0.0448 | |
| Eutectic-1 | 429.00 | |||
| (exp.) | 26.95 | −0.43 | 0.0628 | |
| (cal.) | 27.38 | |||
| Eutectic-2 | 393.62 | |||
| (exp.) | 22.06 | −4.11 | 0.0560 | |
| (cal.) | 26.17 | |||
| APPABA (1:1) | 439.88 | 34.03 | 0.0774 |
| Component | α | σ (erg cm−2) | γ (erg cm−2) |
|---|---|---|---|
| AP—PABA system | |||
| AP | 5.53 | 38.91 | 77.83 |
| PABA | 8.38 | 39.92 | 79.85 |
| Eutectic-1 | 7.55 | 39.67 | 79.34 |
| Eutectic-2 | 6.73 | 39.82 | 79.65 |
| APPABA (1:1) | 9.35 | 39.42 | 78.84 |
| Component | gE (kJ mol−1) | hE (kJ mol−1) | sE (J mol−1K−1) |
|---|---|---|---|
| AP—PABA system | |||
| Eutectic-1 | 0.36 | 6.73 | 0.0149 |
| Eutectic-2 | 1.22 | 4.02 | 0.0071 |
| Concentrations | Synthesized Compound and Antibiotics | E. coli | P. aeruginosa | S. aureus MRSA | S. aureus | K. aerogenes | S. boydii | P. azotoformans | E. cloacae | B. paludis |
|---|---|---|---|---|---|---|---|---|---|---|
| 100 µg/mL | APPABA | 15 | 13 | 16 | 13 | 13 | 12 | 8 | 9 | 15 |
| Chloramphenicol | 13 | 10 | 0.3 | 8 | 7 | 7 | 6 | 6 | 6 | |
| Ampicillin | 13 | 14 | 0 | 14 | 6 | 4 | 10 | 4 | 4 | |
| Tetracycline | 12 | 9 | 18.4 | 11 | 6 | 4 | 5 | 2 | 3 | |
| 10 µg/mL | APPABA | 8 | 11 | 8 | 8 | 8 | 10 | 6 | 3 | 9 |
| Chloramphenicol | 8 | 7 | 0 | 6 | 5 | 5 | 2 | 2 | 1 | |
| Ampicillin | 9 | 10 | 0 | 10 | 4 | 3 | 3 | 2 | 1 | |
| Tetracycline | 8 | 8 | 12.4 | 8 | 3 | 3 | 3 | 1 | 1 | |
| 1 µg/mL | APPABA | 6 | 8 | 6 | 7 | 6 | 3 | 5 | 2 | 6 |
| Chloramphenicol | 3 | 6 | 0 | 5 | 4 | 4 | 1 | 1 | 0 | |
| Ampicillin | 3 | 7 | 0 | 6 | 3 | 2 | 2 | 1 | 1 | |
| Tetracycline | 6 | 7 | 0.2 | 5 | 1 | 2 | 1 | 0 | 0 | |
| 0.1 µg/mL | APPABA | 4 | 7 | 5 | 5 | 6 | 2 | 2 | 2 | 5 |
| Chloramphenicol | 3 | 4 | 0 | 4 | 2 | 2 | 0 | 0 | 0 | |
| Ampicillin | 2 | 5 | 0 | 5 | 1 | 2 | 0 | 0 | 0 | |
| Tetracycline | 5 | 5 | 0 | 2 | 1 | 1 | 0 | 0 | 0 | |
| Control | APPABA | 3 | 3 | 2 | 2 | 1 | 1 | 1 | 1 | 2 |
| Chloramphenicol | 2 | 3 | 0.1 | 2 | 2 | 2 | 0.5 | 0.7 | 0.5 | |
| Ampicillin | 2 | 3 | 0 | 3 | 1 | 1 | 0.7 | 0.5 | 0.5 | |
| Tetracycline | 3 | 2 | 0.1 | 2 | 0.6 | 0.8 | 0.7 | 0.6 | 0.5 |
Disclaimer/Publisher’s Note: The statements, opinions and data contained in all publications are solely those of the individual author(s) and contributor(s) and not of MDPI and/or the editor(s). MDPI and/or the editor(s) disclaim responsibility for any injury to people or property resulting from any ideas, methods, instructions or products referred to in the content. |
© 2025 by the authors. Licensee MDPI, Basel, Switzerland. This article is an open access article distributed under the terms and conditions of the Creative Commons Attribution (CC BY) license (https://creativecommons.org/licenses/by/4.0/).
Share and Cite
Rai, A.; Chaudhary, S.; Dube, S.P.; Bajda, S.; Raghuwanshi, R.; Mishra, S.K.; Palumbo, G.; Rai, R.N. Green Solid-State Synthesis of Antibacterial Binary Organic Material: Crystal Growth, Physicochemical Properties, Thermal Study, Antibacterial Activity, and Hirshfeld Surface Analysis. Int. J. Mol. Sci. 2025, 26, 5509. https://doi.org/10.3390/ijms26125509
Rai A, Chaudhary S, Dube SP, Bajda S, Raghuwanshi R, Mishra SK, Palumbo G, Rai RN. Green Solid-State Synthesis of Antibacterial Binary Organic Material: Crystal Growth, Physicochemical Properties, Thermal Study, Antibacterial Activity, and Hirshfeld Surface Analysis. International Journal of Molecular Sciences. 2025; 26(12):5509. https://doi.org/10.3390/ijms26125509
Chicago/Turabian StyleRai, Adarsh, Sumit Chaudhary, Surya Prakash Dube, Szymon Bajda, Richa Raghuwanshi, Shiva Kant Mishra, Gaetano Palumbo, and Rama Nand Rai. 2025. "Green Solid-State Synthesis of Antibacterial Binary Organic Material: Crystal Growth, Physicochemical Properties, Thermal Study, Antibacterial Activity, and Hirshfeld Surface Analysis" International Journal of Molecular Sciences 26, no. 12: 5509. https://doi.org/10.3390/ijms26125509
APA StyleRai, A., Chaudhary, S., Dube, S. P., Bajda, S., Raghuwanshi, R., Mishra, S. K., Palumbo, G., & Rai, R. N. (2025). Green Solid-State Synthesis of Antibacterial Binary Organic Material: Crystal Growth, Physicochemical Properties, Thermal Study, Antibacterial Activity, and Hirshfeld Surface Analysis. International Journal of Molecular Sciences, 26(12), 5509. https://doi.org/10.3390/ijms26125509

